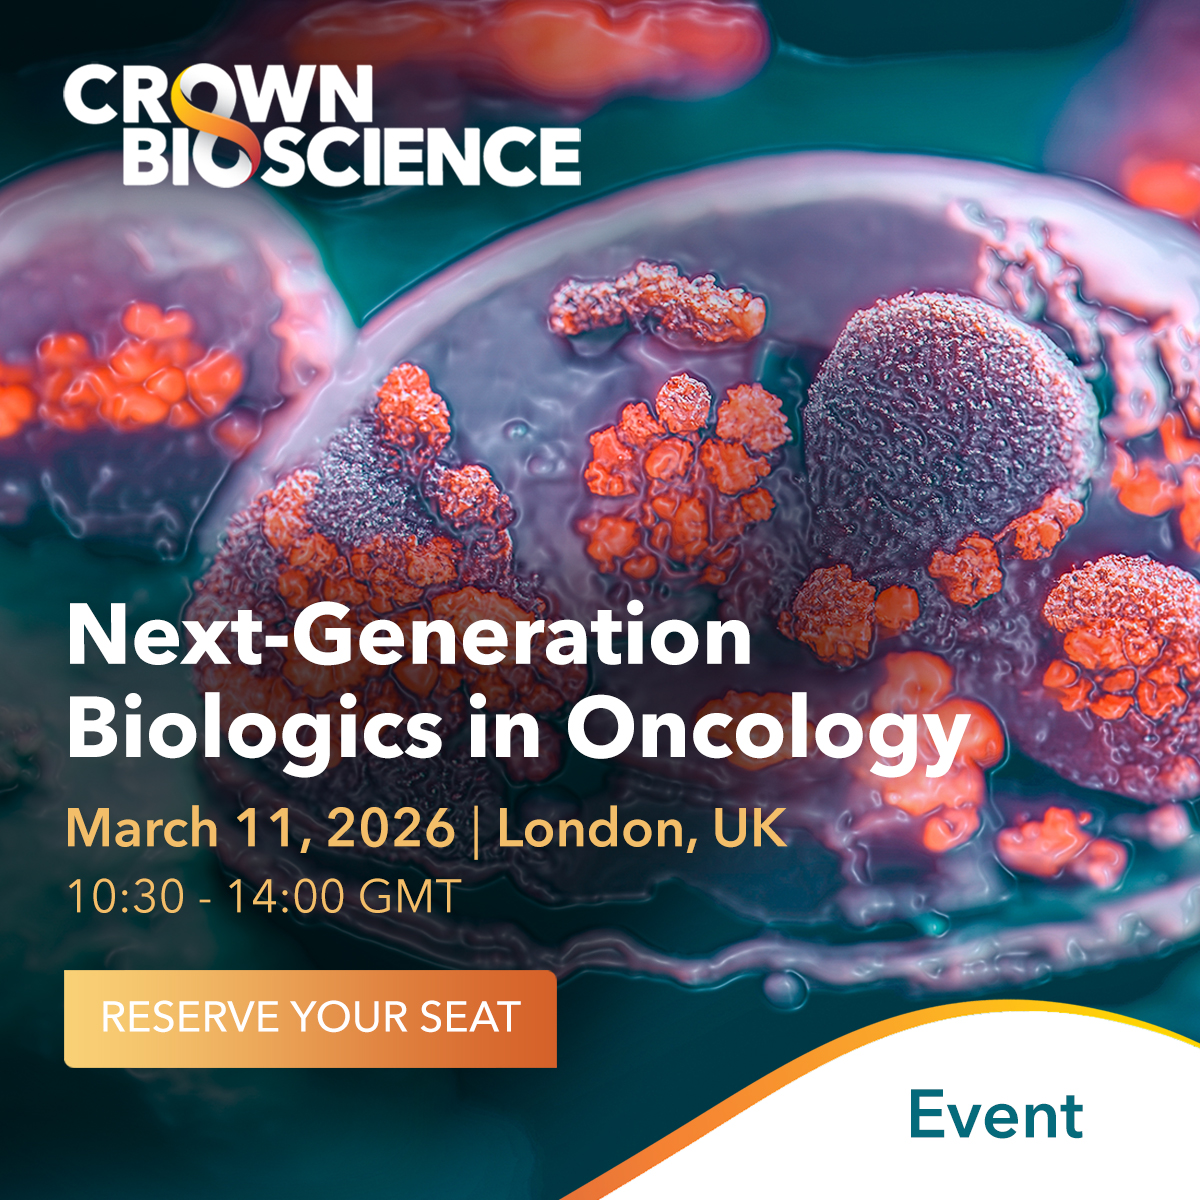
Crown Bioscience tweet media

THE 3R LÄND Conference explores cutting-edge advancements in this ever-evolving field, and we’re thrilled to announce our Director of Scientific Engagement and Consultancy Nataliia Beztsinna will be in attendance.
Schedule a meeting: hubs.la/Q047yq8V0

English